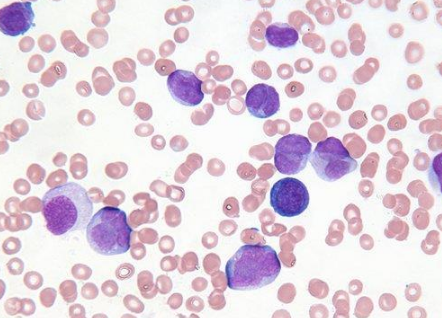

【资讯导读】达施纳,也称为尼洛替尼胶囊,通常适用于费城染色体阳性慢性粒细胞白血病(Ph CML)慢性或加速成人患者,这些患者对以前的治疗(包括伊马替尼)有耐药性或不耐受。达施内的优势主要表
达施纳,也称为尼洛替尼胶囊,通常适用于费城染色体阳性慢性粒细胞白血病(PhCML)慢性或加速成人患者,这些患者对以前的治疗(包括伊马替尼)有耐药性或不耐受。
达施纳的优势主要表现在以下几个方面:
与格列卫相比,达希纳具有更高的安全性和更少的副作用,并且患者服用达希纳后具有更少的耐药性或耐受性。此外,达希纳适合对格列卫耐药或不耐受的患者。
正是由于各种优势,达希纳被认为是格列卫的升级版。然而,这并不是说由于达施内的优势,患者在选择药物时完全放弃了格列卫。一般来说,我们建议白血病患者先选择格列卫,如果出现耐药性或不耐受,那么就选择达
达施纳,以更好地发挥达达希纳的“升级版”的作用。
使用达施纳时应该注意什么?
1.胆汁主要由肝脏代谢,可引起胆红素、谷丙转氨酶和碱性磷酸酶升高。因此,肝损伤患者应该小心使用。 2.达希纳将延长心室复极。心电图检查会发现QT间期延长。延长的QT间期将导致尖端扭转型室性心动过速,这可能导致晕厥、痉挛或死亡。一些研究发现,接受达施内治疗的患者的猝死率为0.6%,猝死的原因可能与心室复极异常有关。3.达希纳可引起血清脂肪酶升高。因此,如果患者有胰腺炎病史,建议在使用达施内时定期监测血清脂肪酶水平,并谨慎使用药物。
4.达希纳含有乳糖,因此如果患者患有遗传性半乳糖不耐受、严重乳糖缺乏症或葡萄糖-半乳糖吸收障碍,则不建议使用达施内。5.不建议低钾血症、低镁血症和长QT综合征患者使用达希纳。如确需用药,在使用本品前,应纠正低钾血症和低镁血症,治疗期间应定期监测电解质,严格监测病情变化,确保用药安全。6.达希纳可能导致血小板减少症、中性粒细胞减少症、贫血等。因此,在使用达希纳的前两个月,患者应每两周进行一次完整的血细胞计数,以后可减少到每月一次。 7.达希纳可引起低磷、低钾、高钾、低钙和低钠血症。因此,在使用达施内之前,应纠正电解质异常,并定期监测电解质状况。 8.在使用达希纳期间,患者不应使用CYP3A4强诱导剂或药物来延长QT间期,以避免药物相互作用。如果有必要使用它,在使用它之前停止达施内,以确保其功效。
达希纳药品详细信息请进入:https://www.inmedf.com/zhongliu/bxb/201949.html